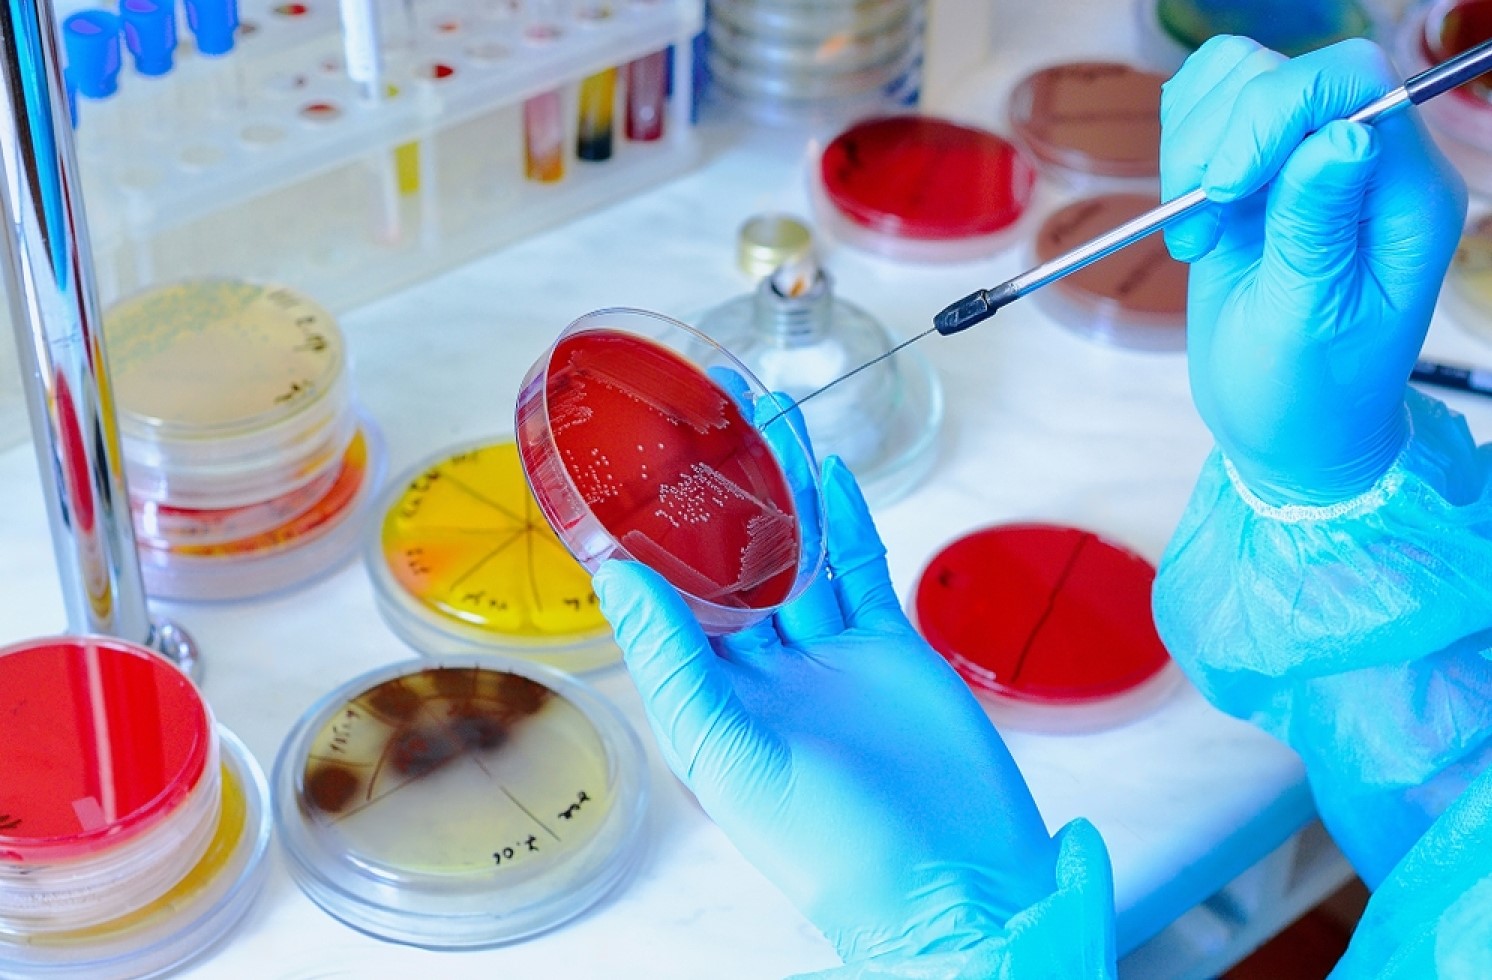
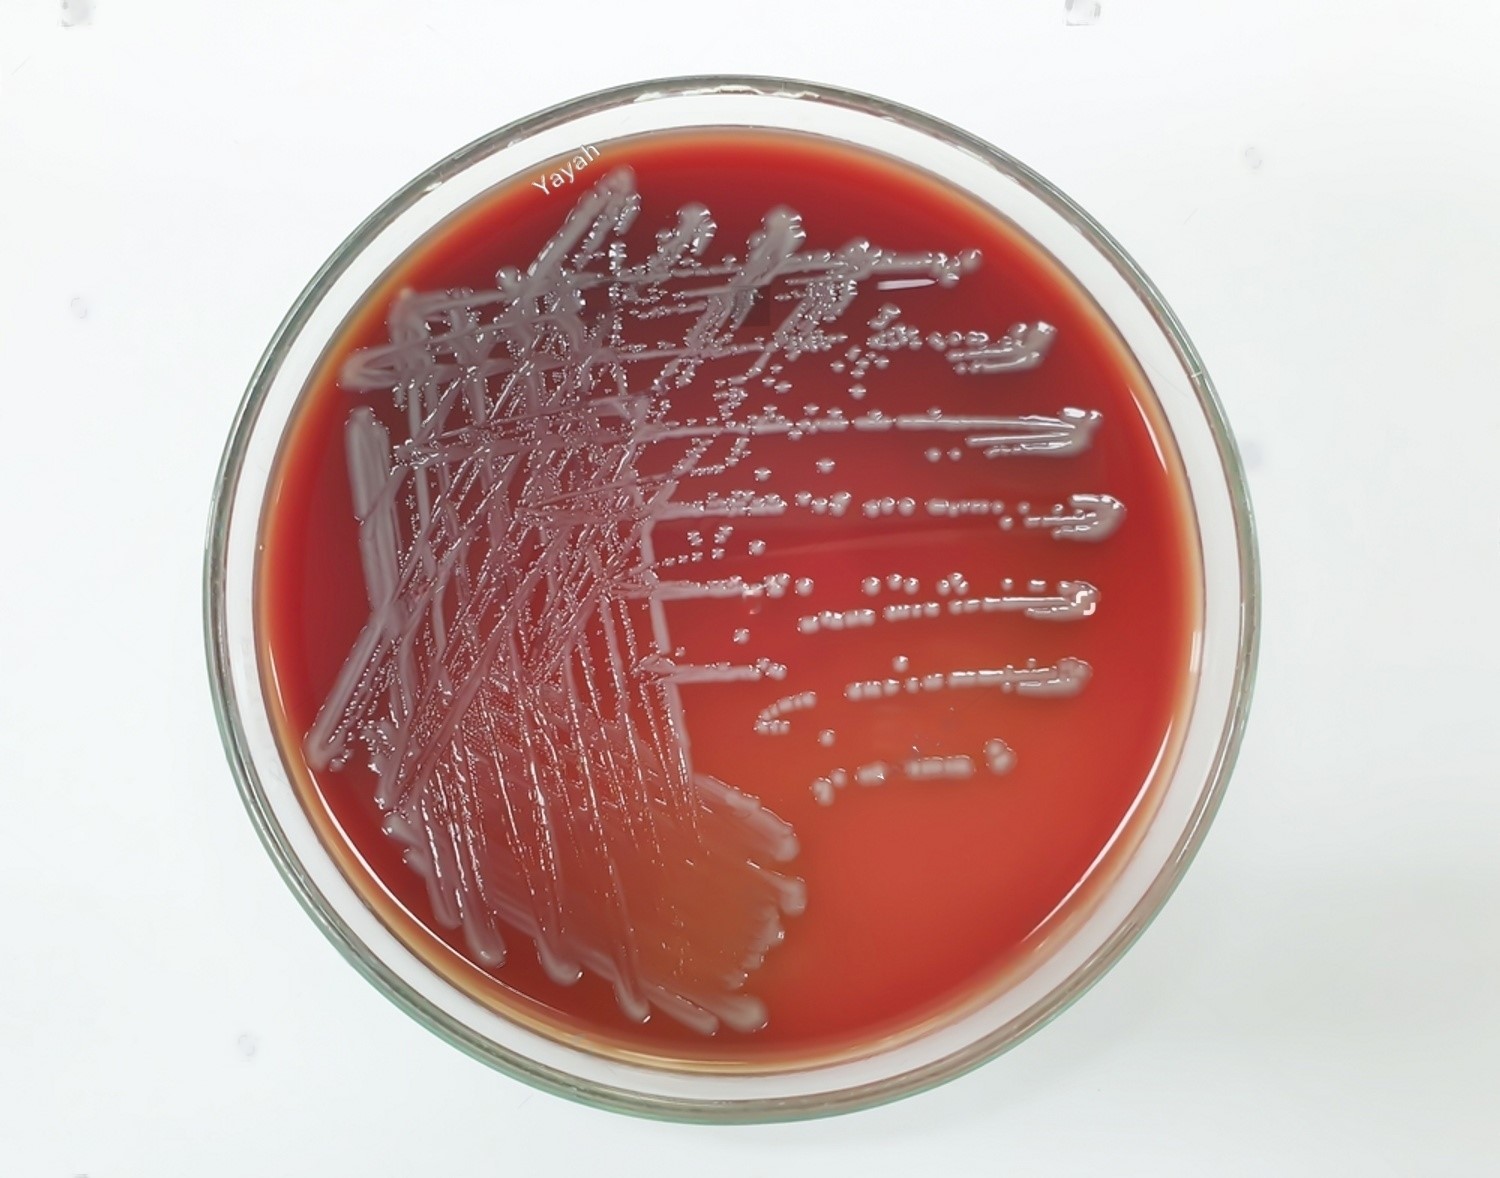

سفارشهای ثبتشده از تاریخ ۱۵ اسفند، پس از تعطیلات نوروز پردازش و ارسال خواهند شد.
در صورت نیاز به دریافت سفارش پیش از تعطیلات، لطفاً خرید خود را قبل از این تاریخ ثبت نمایید.
در صورت نیاز به دریافت سفارش پیش از تعطیلات، لطفاً خرید خود را قبل از این تاریخ ثبت نمایید.
جستجوهای قبلی
جستجوهای پرطرفدار
کشت سلول
الکتروشوک قلبی
استافیلوکوکوس
ساینسبازار | کارگزار رسمی آموزشی پارک سلامت دانشگاه علوم پزشکی مشهد | آنلاین شاپ دانشگاهی | خدمات تخصصی آزمایشگاهی (میکروبی، سلولی، مولکولی و نانوفناوری) | منتورینگ پژوهشی | دورههای آموزشی پژوهانه، فناورانه و کسبوکار با گواهی معتبر | تماس: 09351245541 - 05137116767